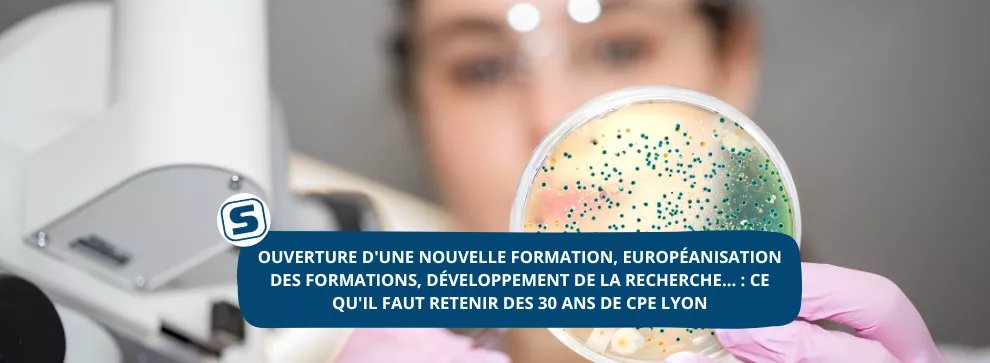

CPE Lyon
@cpelyon
😴 Compte en sommeil 😴 Compte officiel de CPE Lyon : école d'ingénieurs en Chimie-génie des procédés, Sciences et technologies du numérique.
ID: 609094124
http://www.cpe.fr 15-06-2012 13:24:12
2,2K Tweet
2,2K Followers
423 Following


CPE Lyon sera présente au salon post-bac Le Figaro Étudiant à Paris ce week-end, sur le stand 141 ! 📅 Le 5 et 6 octobre ⏲Samedi : 10H- 18H / Dimanche : 10H - 17H 📍Espace Champerret, 6 Rue Jean Oestreicher, 75017 Paris ! Pour s'inscrire👉 bit.ly/3zLEPN0


CPE Lyon sera présente au salon de l'Etudiant à Paris ce week-end, sur le stand R31 ! Pour infos : 📅Le Samedi 12 octobre et le dimanche 13 octobre ⏲De 10H- 18H 📍Porte de Versailles, Paris, sur le stand R31 ! Inscrivez-vous gratuitement 📷 …andes-ecoles-paris.salon.letudiant.fr






🤓 Ecoles, programmes, épreuves, infos pratiques : tout ce qu’il faut savoir pour passer le concours Concours Puissance Alpha 2025 se trouve ici 👇 mondedesgrandesecoles.fr/puissance-alph…


CPE Lyon sera présente au salon de l'Etudiant à Marseille le 9 novembre, au stand B26 ! 📅Samedi 9 novembre 2024 ⏲9:00 – 17:00 📍Parc Chanot – Palais de l’Europe – Hall 8 Rond-point du Prado 13008 Marseille, sur le stand B26 ! Pour s'inscrire 👉…s-ecoles-marseille.salon.letudiant.fr





CPE Lyon sera présente au salon de l'Etudiant à Grenoble le 29 & 30 novembre, au stand n°E38 ! 👩🔬 Pour infos : 📅29 & 30 novembre ⏲09:00 – 17:00 📍ALPEXPO Hall 89 Avenue d'Innsbrück, B.P. 2408 38034 GRENOBLE Inscrivez-vous gratuitement 👉 …-etudiant-grenoble.salon.letudiant.fr


📣Ouverture #Parcoursup aujourd'hui ! Pour accéder aux Classes préparatoires associées CPE Lyon - Institution des Chartreux, inscrivez-vous au Concours Concours Puissance Alpha sur Parcoursup ! Aux choix : 🧪Chimie et Procédés OU 👩💻Sciences du numérique >cpe.fr